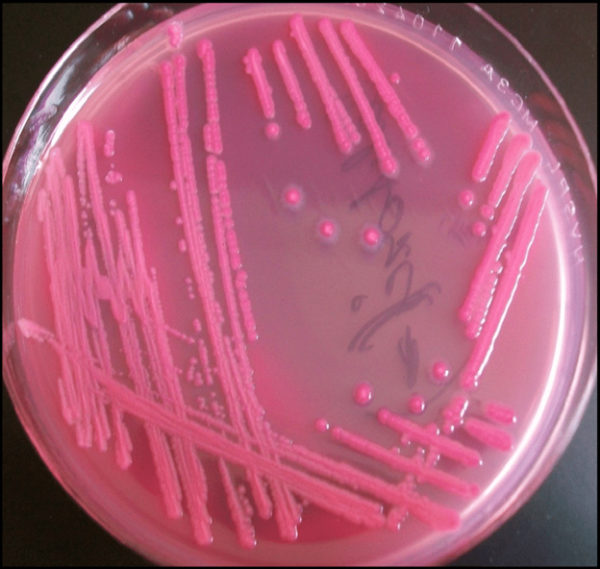
Причины появления E. coli в урине

Бактерия Escherichia coli, часто встречающаяся в моче, является одной из основных причин инфекций мочевыводящих путей. В статье рассмотрим источники этой бактерии, сложности в лечении и меры для эффективной борьбы с ней. Также обсудим особенности передачи E. coli и рекомендации для беременных женщин, что поможет читателям понять риски и способы профилактики. Эта информация будет полезна пациентам и медицинским специалистам, стремящимся повысить осведомленность о проблеме.
Роль кишечной палочки в организме
Многие считают, что Escherichia coli является исключительно вредным микроорганизмом, однако это не совсем так. Существует множество штаммов и их мутантов, среди которых одни являются комменсалами (сосуществуют в симбиозе), а другие могут вызывать кишечные инфекции и различные заболевания у человека.
Медицинские препараты (лекарства, витамины, БАД) упоминаются здесь только в информационных целях. Мы настоятельно рекомендуем не использовать их без консультации с врачом. Рекомендуем ознакомиться с материалом: «Почему нельзя принимать медицинские препараты без назначения врача?».
Некоторые штаммы Эшерихии обладают антагонистическими свойствами, что помогает им препятствовать размножению патогенных грибов и других микроорганизмов. Определенные биотипы способны синтезировать витамин В12, что позволяет удовлетворять потребности организма человека в этом веществе. Эшерихия также участвует в обмене жирных кислот и способствует лучшему усвоению кальция и железа.
Патогенные свойства Эшерихии проявляются при значительном снижении иммунной защиты организма. В таких случаях колонии бактерий начинают увеличиваться, распространяясь на другие органы и вызывая воспалительные процессы.
Врачи отмечают, что Escherichia coli, или кишечная палочка, является одной из самых распространенных бактерий, обитающих в кишечнике человека. Однако, когда эта бактерия попадает в мочу, это может свидетельствовать о наличии инфекции мочевыводящих путей. Врачи объясняют, что источником инфекции часто становятся собственные бактерии пациента, которые могут проникнуть в мочевыводящие пути из кишечника. Это может произойти, например, при неправильной гигиене, особенно у женщин, из-за анатомических особенностей. Также риск увеличивается при наличии мочевых катетеров, ослаблении иммунной системы или хронических заболеваниях. Важно своевременно обращаться к врачу при появлении симптомов, таких как боль при мочеиспускании или частые позывы, чтобы избежать осложнений и получить необходимое лечение.
https://youtube.com/watch?v=LKVr3yAk048
Причины появления E. coli в урине
Кишечная палочка представляет собой очень мелкий микроорганизм. Обнаружить ее в моче возможно лишь в условиях лаборатории.
Факторы, способствующие появлению Escherichia в моче:
- Неправильная подготовка к анализу. Ненадлежащая гигиена половых органов и использование нестерильного контейнера могут привести к ложноположительным результатам. Врачи учитывают другие результаты исследований и могут назначить повторный тест.
- Недостаточная гигиена. Редкое мытье половых органов способствует размножению Эшерихии, которая может попадать из ануса. Кровь и моча создают благоприятные условия для Escherichia, и у женщин, которые не следят за гигиеной во время менструации, может развиться бактериурия.
- Беспорядочные половые связи. Частая смена партнеров и незащищенный секс нарушают микрофлору уретры. Это ослабляет защитные функции мочевыводящих путей, что ведет к увеличению количества патогенных микроорганизмов.
- Гормональные сбои. При заболеваниях эндокринной системы (например, сахарный диабет, ожирение), а также в период беременности и менопаузы происходит гормональный дисбаланс, что снижает иммунные силы организма. В результате он становится менее устойчивым к воздействию патогенных бактерий.
- Затрудненный отток мочи. Застой мочи в мочеточниках и мочевом пузыре способствует размножению вредоносной флоры.
Неправильное питание и избыточный вес могут нарушать работу органов пищеварительной системы. E. coli из толстой кишки может распространяться в кишечник и далее на другие органы.
| Причина появления E. coli в моче | Механизм попадания | Факторы риска |
|---|---|---|
| Несоблюдение правил гигиены | Перенос бактерий из области ануса в уретру | Неправильное подтирание (сзади вперед), редкая смена нижнего белья, использование агрессивных средств гигиены |
| Анатомические особенности | Близость уретры к анусу у женщин | Короткая уретра у женщин, что облегчает попадание бактерий |
| Сексуальная активность | Механическое перемещение бактерий | Секс без использования презервативов, частая смена партнеров, анальный секс с последующим вагинальным |
| Застой мочи | Создание благоприятной среды для размножения бактерий | Редкое мочеиспускание, неполное опорожнение мочевого пузыря, камни в почках или мочевом пузыре, стриктуры уретры |
| Ослабленный иммунитет | Снижение способности организма бороться с инфекциями | Сахарный диабет, ВИЧ, прием иммуносупрессивных препаратов, беременность, пожилой возраст |
| Медицинские манипуляции | Внесение бактерий извне | Катетеризация мочевого пузыря, цистоскопия, операции на органах мочеполовой системы |
| Заболевания кишечника | Распространение бактерий из кишечника | Дисбактериоз, воспалительные заболевания кишечника (например, болезнь Крона, язвенный колит) |
| Беременность | Гормональные изменения и давление на мочевой пузырь | Расширение мочеточников, снижение тонуса мочевого пузыря, что способствует застою мочи |
Как Escherichia coli попадает в мочу
Резервуаром для Escherichia coli является человек. Этот микроорганизм начинает заселять организм, а именно толстую кишку, с момента, когда ребенок начинает получать смешанное питание. На протяжении жизни происходит постоянная смена штаммов Эшерихии, на что влияют такие факторы, как рацион питания, перенесенные инфекции, применение антибиотиков и другие обстоятельства.
В здоровом организме E. coli обитает в желудочно-кишечном тракте (в основном в дистальном отделе кишечника) в количестве 10^6-10^8 КОЕ/г. Несмотря на то, что привычная среда обитания этого микроорганизма находится в непосредственной близости к мочевыводящим путям, E. coli в нормальных условиях не должны присутствовать в моче.
Появление патогенных микроорганизмов в моче называется бактериурией. Из всех вредных бактерий именно Эшерихия встречается наиболее часто.
Escherichia может попасть в мочу несколькими путями:
- Восходящий — бактерии проникают через уретру. Этот путь особенно характерен для женщин из-за анатомических особенностей. Наличие мочевого катетера также увеличивает риск инфицирования мочи.
- Нисходящий — E. coli проникают из почек и мочеточников. Бактериурия может возникать при стенозе мочеточников или мочекаменной болезни.
- Лимфогенный — Эшерихия распространяется через лимфатические узлы из близлежащих инфекционных очагов.
- Гематогенный — грамотрицательные бактерии проникают в мочу через кровеносную систему.
Escherichia проникает одним из указанных путей и быстро распространяется на соседние органы.
https://youtube.com/watch?v=muycoXdYOp4
Какие заболевания вызывает кишечная палочка
Escherichia могут быть причиной различных заболеваний.
Обнаружение кишечной палочки в моче обычно свидетельствует о наличии инфекций мочеполовой системы:
- пиелонефрит;
- цистит;
- неспецифический уретрит;
- бактериальный простатит;
- баланопостит;
- вагинит;
- вульвовагинит;
- цервицит.
В редких случаях могут возникнуть орхит и эпидидимит.
Вызывает ли бактерия E. coli цистит
Цистит представляет собой воспалительный процесс, затрагивающий стенки мочевого пузыря. Основной причиной данного заболевания является инфекция. Даже если изначально воспаление вызвано воздействием химических веществ или медикаментов, вскоре к процессу присоединяется инфекция.
Escherichia coli является одной из наиболее частых причин цистита и инфекций мочевого пузыря, составляя до 75% всех случаев. Этот микроорганизм проникает в мочевыводящую систему из кишечника. У женщин, благодаря более короткой уретре, расположенной близко к анусу, риск развития инфекций мочевыводящих путей, включая цистит, значительно выше.
Слизистая оболочка мочевого пузыря обладает хорошей защитой от инфекций, поэтому простое инфицирование не всегда приводит к развитию заболевания. Ключевую роль в возникновении цистита играет снижение иммунной защиты организма перед воздействием патогенных факторов. В условиях ослабленного иммунитета наблюдается активный рост E. coli.
https://youtube.com/watch?v=TvF-hO9wiwU
Как передаются инфекции, вызываемые Escherichia coli?
Основные способы передачи заболеваний, связанных с кишечной палочкой, происходят через орально-фекальный путь. Бактерия в значительных количествах попадает в кишечник через немытые руки, продукты питания и загрязненную питьевую воду. Из желудочно-кишечного тракта она может проникать в мочевую систему.
Факторы, способствующие проникновению палочки в уретру и её активному размножению:
- Неправильное подтирание после дефекации. При вытирании от ануса к уретре кишечная палочка может перемещаться из заднего прохода в мочеиспускательный канал.
- Неправильная техника интимной гигиены. Половые органы следует мыть проточной водой; при подмывании в тазике бактерии из анальной области могут перейти на наружные половые органы и в уретру.
- Анальный секс без использования презерватива. Бактерии из заднего прохода могут попасть в мужскую уретру или влагалище, если после анального секса происходит вагинальный.
- Половые контакты с партнёром, имеющим венерические заболевания. Другие патогенные микроорганизмы могут вызывать воспалительные процессы в мочеполовых органах, ослабляя иммунитет и способствуя росту патогенных штаммов E. coli.
При ослаблении организма инфекции развиваются очень быстро.
Признаки заболевания. Когда назначают обследование?
Симптомы бактериурии не являются специфическими и могут наблюдаться при различных инфекционно-воспалительных заболеваниях.
Симптоматика зависит от локализации и штамма E. coli, вызывающего инфекцию, и включает в себя:
- дискомфорт и жжение при мочеиспускании;
- нарушения в процессе мочеиспускания;
- изменения в цвете мочи и появление неприятного запаха;
- боли в области живота и поясницы.
При возникновении первых признаков следует незамедлительно обратиться к врачу.
Определение кишечной палочки осуществляется с помощью лабораторных исследований:
- Микроскопия мочи позволяет проанализировать состав урины и степень воспалительного процесса.
- Тест на наличие нитритов – специальные мочевые тест-полоски меняют цвет при обнаружении нитритов.
- Бактериологический посев мочи помогает выявить виды бактерий и их количество. Этот анализ также позволяет обнаружить другие патогенные микроорганизмы, однако его недостатком является длительное ожидание результатов – до 5 дней.
- Тест на чувствительность к антибиотикам назначается при обнаружении патогенной флоры в количестве более 103. Это исследование определяет устойчивость E. coli и других патогенных бактерий к различным антибактериальным препаратам и выявляет, к каким из них они чувствительны.
Кроме того, могут быть проведены УЗИ почек, органов малого таза и простаты. Женщинам обязательно требуется консультация гинеколога.
Лечение кишечной палочки в моче
Лечение сосредоточено на ликвидации источника инфекции, восстановлении нормального мочеиспускания и укреплении иммунной системы. Подбор терапии осуществляется индивидуально, принимая во внимание локализацию заболевания, его тяжесть, а также возраст и общее состояние пациента.
При назначении лечения также принимаются во внимание ранее перенесенные инфекции мочеполовой системы и результаты предыдущего лечения.
Схема терапии
Коррекция бактериурии осуществляется с помощью антибактериальных средств, которые выбираются на основе результатов антибиотикограммы.
Терапевтическая схема зависит от заболевания, вызванного E. coli.
| Заболевание | Лекарственные средства |
| Пиелонефрит | Пенициллины: Ампициллин, Панклав; Цефалоспорины: Цефиксим, Цефтибутен; Фторхинолоны: Левофлоксацин |
| Цистит | Тетрациклины: Олететрин; Нитрофураны: Нитрофурантоин, Фурадонин |
| Уретрит | Пенициллины: Амоксиклав; Макролиды: Хемомицин |
| Инфекции половой системы | При простатите назначают макролиды и фторхинолоны; при вагинитах и цервицитах применяют метронидазол и клиндамицин |
Для укрепления иммунной системы рекомендуется использование интерферонов и иммуномодуляторов.
Как проходит лечение у беременных женщин
При выборе лекарственных средств для терапии инфекций мочевыводящих путей необходимо учитывать потенциальный риск для плода:
- Полусинтетические пенициллины имеют широкий спектр действия. Наилучшие результаты достигаются при использовании комбинаций пенициллинов с клавулановой кислотой.
- Цефалоспорины второго поколения демонстрируют хорошие терапевтические результаты и вызывают меньше побочных эффектов.
- Нитрофураны. У данного класса антибиотиков редко наблюдается развитие резистентности у патогенной флоры.
Класс безопасности препаратов должен быть либо А, либо В.
Особенности терапии у детей
Педиатр выбирает лекарства, основываясь на возрасте ребенка, а дозировка определяется в зависимости от его веса. Для детей обычно назначают защищенные пенициллины, цефалоспорины, Фосфомицин и сульфаниламиды в различных комбинациях. Продолжительность лечения не должна превышать 7 дней.
Почему не удается вылечить E. coli?
Рецидивирующие инфекции мочеполовой системы, вызванные кишечной палочкой, часто возникают из-за неправильного лечения. Неправильно подобранные препараты или их дозировка могут снизить количество патогенных штаммов E. coli, но не устраняют их полностью.
Некоторые пациенты, по незнанию, не информируют врача о том, что недавно принимали те же антибиотики, которые он собирается назначить. Например, если человек проходил курс лечения пенициллинами, то повторное назначение этих препаратов возможно не ранее чем через три месяца после последнего приема.
Длительное применение антибиотиков может привести к дисбактериозам. Нарушение баланса кишечной микрофлоры способствует росту патогенных микроорганизмов. Лечением Escherichia должен заниматься квалифицированный специалист, а пациенту следует строго следовать всем рекомендациям врача. Только такой комплексный подход поможет избавиться от инфекций, вызванных кишечной палочкой.
Источники
- Уропатогенные штаммы Escherichia coli. Семейство Enterobacteriaceae. Джон Е. Беннет, доктор медицины, в книге «Принципы и практика инфекционных заболеваний» под редакцией Манделла, Дугласа и Беннета, 2020 год.
- Исследование Escherichia coli, выделенной из мочи пациентов в различных клинических условиях. Научная статья в области «Клиническая медицина». Эльмира Муллагалиевна Аминева, Лариса Израилевна Бахарева.
- Чувствительность к антибиотикам штаммов Escherichia coli, полученных от пациентов с мочекаменной болезнью. Д.С. Смольянинова, Г.А. Батищева, Н.В. Габбасова, Н.Ю. Гончарова. Журнал «Современные проблемы науки и образования». – 2020. – № 5. Дата публикации: 15.10.2020.
- Антибиотикорезистентность у урологических пациентов с воспалительными заболеваниями верхних мочевыводящих путей. А.Ю. Бочкарев, С.В. Костюков, Е.И. Шаматрина, Д.С. Меринов. Выпуск №2, 2019 – стр. 106-110.
- E. coli как условно-патогенные бактерии кишечника человека. Н.А. Ильина, Е.А. Карпеева, И.Т. Гусева. Журнал «Современные наукоемкие технологии». – 2008. – № 9 – С. 60-62.
- Проблемы лечения рецидивирующих инфекций мочевых путей. РМЖ. №12 от 03.06.2009, стр. 841. Автор: Т.С. Перепанова.
Профилактика инфекций, вызванных E. coli
Профилактика инфекций, вызванных Escherichia coli, является важной задачей как для индивидуального здоровья, так и для общественного благополучия. Существует несколько стратегий, которые могут помочь снизить риск заражения этой бактерией, особенно в контексте мочевыводящих путей.
1. Соблюдение гигиенических норм: Одним из основных способов предотвращения инфекций является соблюдение правил личной гигиены. Регулярное мытье рук с мылом, особенно после посещения туалета и перед едой, значительно снижает риск передачи бактерий. Также важно поддерживать чистоту в области гениталий, что особенно актуально для женщин, так как анатомические особенности делают их более уязвимыми к инфекциям.
2. Правильное употребление пищи: Поскольку E. coli может быть передана через contaminated food, важно следить за качеством продуктов. Необходимо тщательно мыть фрукты и овощи, а также готовить мясо до полной готовности. Избегайте употребления сырого или недостаточно термически обработанного мяса, особенно говядины, так как именно в нем часто встречаются патогенные штаммы E. coli.
3. Увлажнение и частое мочеиспускание: Поддержание адекватного уровня гидратации помогает предотвратить инфекции мочевыводящих путей. Регулярное мочеиспускание способствует выведению бактерий из мочевого пузыря, что снижает вероятность их размножения. Рекомендуется пить достаточное количество воды, особенно в жаркую погоду или при физической активности.
4. Избегание раздражителей: Некоторые продукты и вещества могут раздражать мочевыводящие пути и способствовать развитию инфекций. К ним относятся кофеин, алкоголь, острые специи и искусственные подсластители. Ограничение их потребления может помочь снизить риск возникновения инфекций.
5. Использование пробиотиков: Пробиотики могут помочь поддерживать здоровую микрофлору кишечника и мочевыводящих путей. Употребление йогуртов и других ферментированных продуктов, содержащих живые культуры, может способствовать укреплению иммунной системы и снижению вероятности инфекций.
6. Консультация с врачом: Если у вас есть предрасположенность к инфекциям мочевыводящих путей, важно регулярно консультироваться с врачом. Специалист может рекомендовать профилактические меры, такие как прием антибиотиков в низких дозах или использование специальных препаратов, которые помогают предотвратить повторные инфекции.
Следуя этим рекомендациям, можно значительно снизить риск заражения Escherichia coli и других патогенных микроорганизмов, что в свою очередь способствует поддержанию здоровья мочевыводящих путей и общего состояния организма.
Роль диеты в контроле уровня E. coli в организме
Диета играет важную роль в поддержании здоровья микрофлоры кишечника и, соответственно, в контроле уровня Escherichia coli (E. coli) в организме. Питание напрямую влияет на состав и разнообразие кишечной флоры, что может способствовать как росту, так и подавлению патогенных штаммов E. coli.
Одним из ключевых факторов является потребление клетчатки. Продукты, богатые клетчаткой, такие как фрукты, овощи, цельнозерновые продукты и бобовые, способствуют росту полезных бактерий, которые могут конкурировать с E. coli за ресурсы и место обитания в кишечнике. Клетчатка также способствует нормализации стула и улучшает общее состояние кишечника, что снижает риск инфекций.
Кроме того, пробиотики, содержащиеся в ферментированных продуктах, таких как йогурт, кефир и квашеная капуста, могут помочь в поддержании здорового баланса микрофлоры. Пробиотики способствуют увеличению числа полезных бактерий, которые могут подавлять рост патогенных штаммов E. coli. Исследования показывают, что регулярное употребление пробиотиков может снижать риск развития инфекций мочевыводящих путей, связанных с E. coli.
С другой стороны, диета, богатая сахаром и обработанными продуктами, может способствовать росту патогенных бактерий, включая E. coli. Высокое содержание сахара может нарушать баланс микрофлоры, способствуя размножению вредных бактерий. Поэтому важно ограничивать потребление сладких и обработанных продуктов, чтобы поддерживать здоровье кишечника.
Также стоит обратить внимание на достаточное потребление жидкости. Вода помогает поддерживать нормальную работу почек и способствует выведению токсинов и бактерий из организма. Недостаток жидкости может привести к обезвоживанию и, как следствие, к увеличению концентрации бактерий в моче.
Наконец, важно учитывать индивидуальные особенности организма. У некоторых людей могут быть специфические реакции на определенные продукты, которые могут способствовать росту E. coli. В таких случаях рекомендуется вести дневник питания и отслеживать, какие продукты могут вызывать проблемы, чтобы корректировать свой рацион.
Таким образом, правильная диета является важным инструментом в контроле уровня E. coli в организме. Сбалансированное питание, богатое клетчаткой и пробиотиками, а также ограничение сахара и обработанных продуктов могут значительно снизить риск инфекций, связанных с этой бактерией.
Исследования и новые методы диагностики E. coli в моче
Исследования, касающиеся бактерии Escherichia coli (E. coli) в моче, активно развиваются благодаря современным достижениям в области микробиологии и медицинской диагностики. E. coli является одной из наиболее распространенных бактерий, обитающих в кишечнике человека и животных, однако некоторые штаммы могут вызывать инфекции мочевыводящих путей (ИМП), что делает их предметом особого внимания.
Одним из ключевых аспектов диагностики E. coli в моче является использование различных методов микробиологического анализа. Традиционно для выявления бактерий в моче применяются посевы на питательные среды, что позволяет определить наличие и количество колоний E. coli. Однако этот метод требует времени, так как результаты могут быть получены только через 24-48 часов.
С развитием молекулярной диагностики появились более быстрые и точные методы, такие как полимеразная цепная реакция (ПЦР). Этот метод позволяет обнаруживать ДНК E. coli в моче всего за несколько часов, что значительно ускоряет процесс диагностики и позволяет врачам быстрее назначать соответствующее лечение. ПЦР также помогает различать патогенные и непатогенные штаммы E. coli, что имеет важное значение для выбора терапии.
Кроме того, в последние годы активно исследуются методы, основанные на использовании биосенсоров. Эти устройства способны обнаруживать E. coli в моче с высокой чувствительностью и специфичностью, что делает их перспективными для использования в клинической практике. Биосенсоры могут быть интегрированы в мобильные приложения, что позволит пациентам самостоятельно контролировать свое состояние и получать рекомендации по лечению.
Также стоит отметить, что исследование генетических маркеров E. coli открывает новые горизонты в понимании патогенеза инфекций мочевыводящих путей. Ученые изучают, какие именно гены способствуют вирулентности бактерий, что может привести к разработке новых методов профилактики и лечения ИМП.
В заключение, исследования E. coli в моче продолжают развиваться, и новые методы диагностики открывают возможности для более раннего и точного выявления инфекций. Это, в свою очередь, способствует улучшению качества медицинской помощи и снижению заболеваемости, связанной с инфекциями мочевыводящих путей.